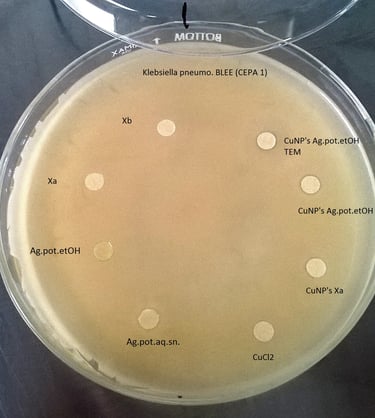

WHO WE ARE?
Passion for cultivation
Hello, my name is Bersain Moreno, I have grown arid zone plants such as cacti, caudex and succulents for 28 years to this day.
Pharmacobiologist Chemist by profession, I completed a Master's Degree in Microbiological Sciences for which I have managed cultures of microorganisms, mainly fungi and bacteria, for 20 years.
Likewise, I worked for 5 years as manager of the Germplasm Bank of the National Forestry Commission, experimenting with various types of orthodox and recalcitrant seeds.
Later I completed a PhD in Nanotechnology where we developed a new technique using green chemistry to carry out the synthesis of metallic nanomaterials, including silver and gold nanoparticles, with various applications. (Quick synthesis of gold nanoparticles at low temperature, by using Agave potatorum extracts, Biosynthesis of gold nanoparticles from Agave potatorum extracts: effect of the solvent in the extraction)
The fusion of all the above has brought me here, to share the passion, technique and knowledge for growing plants from arid areas.
Throughout this journey I have had to develop solutions to improve processes such as seed collection, germplasm storage and the cultivation of cacti and succulents. To achieve this I have needed accessories or tools that are not available on the market, which is why I have worked on the design of my own accessories and devices, which I am sure can be of interest and useful for the activities carried out by other enthusiasts and professionals in the propagation and cultivation of plants in arid areas. Under this innovative concept we are developing a nanotechnological germplasm protection system called Nanosilver Germplasm Protection, with the purpose of maintaining the germplasm collected in the form of seeds in the best possible conditions for long periods of time.
Welcome to the Aridarium experience, legendary plants.
Bersain Moreno

Connect with us! #CultivosLegendarios
Know us
Legendary plants, Experience and Passion for cultivation
Aridarium, legendary plants, is a company that develops solutions to improve the growing experience of plants from arid areas and succulents.
We are committed to providing the best quality of products to our customers, at the moment we are not suppliers of plants or seeds.
Our accessories are made with the most resistant materials, we are creating innovative and highly useful products specially designed for the cultivation of plants in arid areas.






Mission: Inspire people to develop their growing skills by providing them with quality innovative tools and products to enrich their experience in maintaining their succulents and arid zone plants.
Vision: to be a leading company in the development of innovative products for professionals and enthusiasts in the art of growing succulents and arid zone plants.

Relevant aspects about the cultivation of plants in arid areas
The cultivation of cacti and succulents presents particular challenges that arise from the special conditions that these plants face in nature, for which they have developed mechanisms and strategies that provide them with resistance against the difficult environmental conditions of their environment, these strategies allow them to survive in hostile environments during dry seasons, such as the presence of tissues specialized in water storage.
This particular way of life that they have acquired generates specific challenges that are often underestimated by the amateur grower, resulting in the development of weak or diseased plants that at any time can irreversibly succumb to death. Therefore, to achieve better cultivation of these species from arid zones, the main factors that must be taken into account in their daily conditions according to the experience I have acquired in their cultivation are:
Type, material and size of container used
Type of substrate used
Hours of light and light intensity that the plant will receive
Temperature ranges
Irrigation regime
Plant size and age
Each of these factors must be considered to achieve the successful cultivation of this type of plants specialized in growing in arid areas.
And it all begins with the correct collection, treatment and storage of germplasm.








Legendary plants, Experience and Passion for cultivation

Astrophytum ornatum
Mammillaria pectinifera

Astrophytum myriostigma







What our buyers say...
”My experience with Aridarium tools has been the best. It has made taking care of the plants much easier for me. Mainly the roots when planting or transplanting from a pot. Very easy to maneuver, resistant and easy to clean. .”
- Daniel Vite
”Beautiful, functional and very resistant! Regardless of your level of experience, they are exactly what you are looking for to make your job easier. “Whoever makes them knows what a cactus and succulent grower needs.”
- Gandhy Salgado
”The tools are useful and functional, they feel comfortable and I advance quickly in growing my cacti"
- José Sanchez
"I liked that the materials are robust and the finishes are quite good, I am just starting to grow succulent plants but these tools are helping me a lot"
- Juan Martínez
”The Aridarium Tool Kit is excellent, it has made my cultivation and transplanting maneuvers much easier, I even use it for my mini orchids as well. “Your acquisition is a great success.”
- Lourdes
”Quite interesting is the way to save seeds for a long time, without losing them due to humidity, a problem that I had had before. The Aridarium fruit and seed collection system is very practical and useful, I highly recommend it.
- David

































